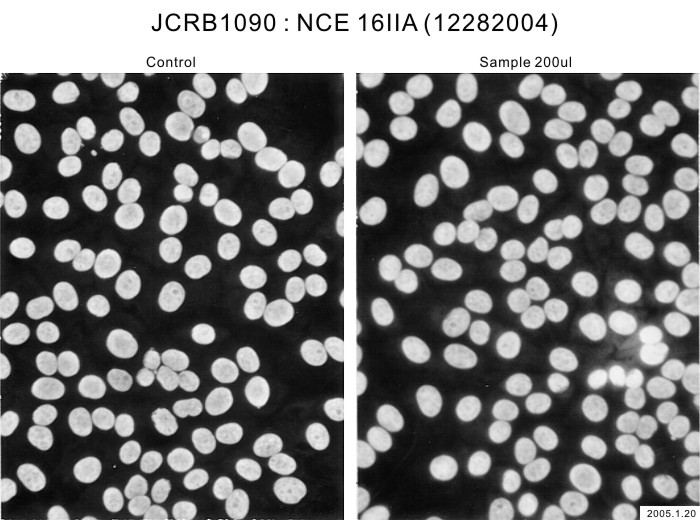

JCRB1090 NCE 16IIA
Cell information
Important Notice(s)Supplements for the Serum free culture medium
Cell type:general cells (View Pricing Information)
| JCRB No. | JCRB1090 | Cell Name | NCE 16IIA |
|---|---|---|---|
| Profile | HPV16 transformed noraml cells derived from human cervix. | Other Name | |
| Animal | human | Strain | |
| Genus | Homo | Species | sapiens |
| Sex | F | Age | adult |
| Identity | available | Tissue for Primary Cancer | uterine cervix |
| Case history | Metastasis | ||
| Tissue Metastasized | Genetics | teromerase positive, HPV16, p75 NTR positive. | |
| Life Span | infinite | Crisis PDL | |
| Morphology | epithelial-like | Character | HPV16 transformed noraml human cells from cervix |
| Classify | transformed | Established by | Yasumoto,S. |
| Registered by | Yasumoto, S. | Regulation for Distribution | Not applied. |
| Comment | Year | 2001 | |
| Medium | MCDB153 medium (0.03 mM Ca2+) with 5 ug/ml insulin, 0.5 ug/ml hydrocortisone, 10 ug/ml transferrin, 0.1 mM phosphorylethanolamine, 0.1 mM ethanolamine, 10 ng/ml EGF and 40-70 ug/ml bovine pituitary extract. | Methods for Passages | Cells are harvested with 0.1% trypsin and 0.1% EDTA. Medium change every 2 days and subculture every 10 days. |
| Cell Number on Passage | 1.5 - 2.4 x 10^5 cells/sq.cm. | Race | Japanese |
| CO2 Conc. | Tissue Sampling | cervix | |
| Tissue Type |
| Detection of virus genome fragment by Real-time PCR | |||||||||
|---|---|---|---|---|---|---|---|---|---|
| Detected DNA Virus | tested | Detected RNA Virus | tested | ||||||
| CMV | - | parvoB19 | - | HCV | - | HTLV-1 | - | ||
| EBV | - | HBV | - | HIV-1 | - | HTLV-2 | - | ||
| HHV6 | - | HTLV-1 | - | HIV-2 | - | HAV | - | ||
| HHV7 | - | HTLV-2 | - |
-/negative. +/positive. nt/not tested. (positive (+) does not immediately mean the production of infectious viral particles.) |
|||||
| BKV | - | HIV-1 | - | ||||||
| JCV | - | HIV-2 | - | ||||||
| ADV | - | HPV18 | - | ||||||
| Notes | |||||||||
| Reference | |
|---|---|
| Pubmed id:12747968 | Gene expression of telomerase related proteins in human normal oral and ectocervical epithelial cells. Fujimoto R,Kamata N,Taki M,Yokoyama K,Tomonari M,Nagayama M,Yasumoto S Oral Oncol. 2003 Jul;39(5):445-52 |
| Images |
|---|
![]() ![]() ![]() ![]() ![]() ![]() ![]() ![]() ![]() ![]() ![]() |
LOT Information
Viability/Growth rate/Cell number are represented as actual values measured at lot presentation in JCRB, but are not guaranteed values. Additionally, the doubling time is a rough value measured during passages.| Cell No. | JCRB1090 | Cell Name | NCE 16IIA |
|---|---|---|---|
| LOT No. | 02182011 | Lot Specification | distribution |
| Medium | MCDB153 medium with 5 ug/ml insulin, 0.5 ug/ml hydrocortisone, 10 ug/ml transferrin, 0.1 mM phosphorylethanolamine, 0.1 mM ethanolamine, 10 ng/ml EGF and 50 ug/ml bovine pituitary extract. | Temperature | 37 C |
| Cell Density at Seeding | 0.75-4.4x10^4 cells/sq.cm | Methods for Passages | Cells were harvested after treatment with 0.1% trypsin and 0.01% EDTA at 10x10^4 cells/sq.cm. |
| Doubling Time | NT | Cell Number in Vial (cells/1ml) | 1.38x10^6 |
| Viability at cell freezing (%) | 93.9 | Antibiotics Used | free |
| Passage Number | p21 | PDL | NT |
| Sterility: MYCOPLASMA | - | Sterility: BACTERIA | - |
| Sterility: FUNGI | - | Isozyme Analysis | NT |
| Chromosome Mode | NT | Chromosome Information | NT |
| Surface Antigen | NT | DNA Profile (STR) | D5S818:12 D13S317:11,12 D7S820:8,11 D16S539:11,12 VWA:16,18 TH01:7 AM:X TPOX:9,12 CSF1PO:11,12 |
| Adhesion | Yes | Exoteric Gene | NT |
| Medium for Freezing | Cell Banker BLC-1(Nihon Zenyaku Industries) | CO2 Conc. | 5 % |
| Viability immediately after thawing (%) | Additional information |
| Images |
|---|
|
|
| Cell No. | JCRB1090 | Cell Name | NCE 16IIA |
|---|---|---|---|
| LOT No. | 12282004 | Lot Specification | distribution |
| Medium | MCDB153 medium with 5 ug/ml insulin, 0.5 ug/ml hydrocortisone, 10 ug/ml transferrin, 0.1 mM phosphorylethanolamine, 0.1 mM ethanolamine, 10 ng/ml EGF and 50 ug/ml bovine pituitary extract. | Temperature | 37 C |
| Cell Density at Seeding | 5.0 x 10^3 cells / sq.cm | Methods for Passages | Cells harvested after treatment with 0.1% trypsin and 0.1% EDTA. Subculture 7-14 days, medium change every 2-3 days. |
| Doubling Time | NT | Cell Number in Vial (cells/1ml) | 1.21x10^6 |
| Viability at cell freezing (%) | 90.7 | Antibiotics Used | NT |
| Passage Number | P14 | PDL | NT |
| Sterility: MYCOPLASMA | - | Sterility: BACTERIA | - |
| Sterility: FUNGI | - | Isozyme Analysis | NT |
| Chromosome Mode | NT | Chromosome Information | NT |
| Surface Antigen | NT | DNA Profile (STR) | D5S818:12 D13S317:11,12 D7S820:8,11 D16S539:11,12 VWA:16,18 TH01:7 AM:X TPOX:9,12 CSF1PO:11,12 |
| Adhesion | Yes | Exoteric Gene | NT |
| Medium for Freezing | One to one mix with Cultue medium and FM-1(containing 10%DMSO) medium. | CO2 Conc. | 5% |
| Viability immediately after thawing (%) | Additional information |
| Images |
|---|
![]() ![]() ![]() ![]() ![]() ![]() ![]() |
| Cell No. | JCRB1090 | Cell Name | NCE 16IIA |
|---|---|---|---|
| LOT No. | 02272014 | Lot Specification | distribution |
| Medium | MCDB153 medium (0.03 mM Ca2+) with 5 ug/ml insulin, 0.5 ug/ml hydrocortisone, 10 ug/ml transferrin, 0.1 mM phosphorylethanolamine, 0.1 mM ethanolamine, 10 ng/ml EGF and 40-70 ug/ml bovine pituitary extract. | Temperature | 37 C |
| Cell Density at Seeding | 1.2 -1.7 x 10^4 cells/mL | Methods for Passages | Cells were harvested after treatment with 0.1% crystelline trypsin, then trypsin activity was terminated 0.1% (final conc.) soybean trypsin inhibitor (Sigma type IS). |
| Doubling Time | Cell Number in Vial (cells/1ml) | 4.4 x 10^5 | |
| Viability at cell freezing (%) | 97.0 | Antibiotics Used | free |
| Passage Number | P16 | PDL | |
| Sterility: MYCOPLASMA | - | Sterility: BACTERIA | - |
| Sterility: FUNGI | - | Isozyme Analysis | Confirmed as human by NP, G6PD, MD. |
| Chromosome Mode | Chromosome Information | ||
| Surface Antigen | DNA Profile (STR) | ||
| Adhesion | Yes | Exoteric Gene | |
| Medium for Freezing | 10% DMSO, 0.1% methylcellulose - culture medium | CO2 Conc. | 5% |
| Viability immediately after thawing (%) | 97.0 | Additional information |